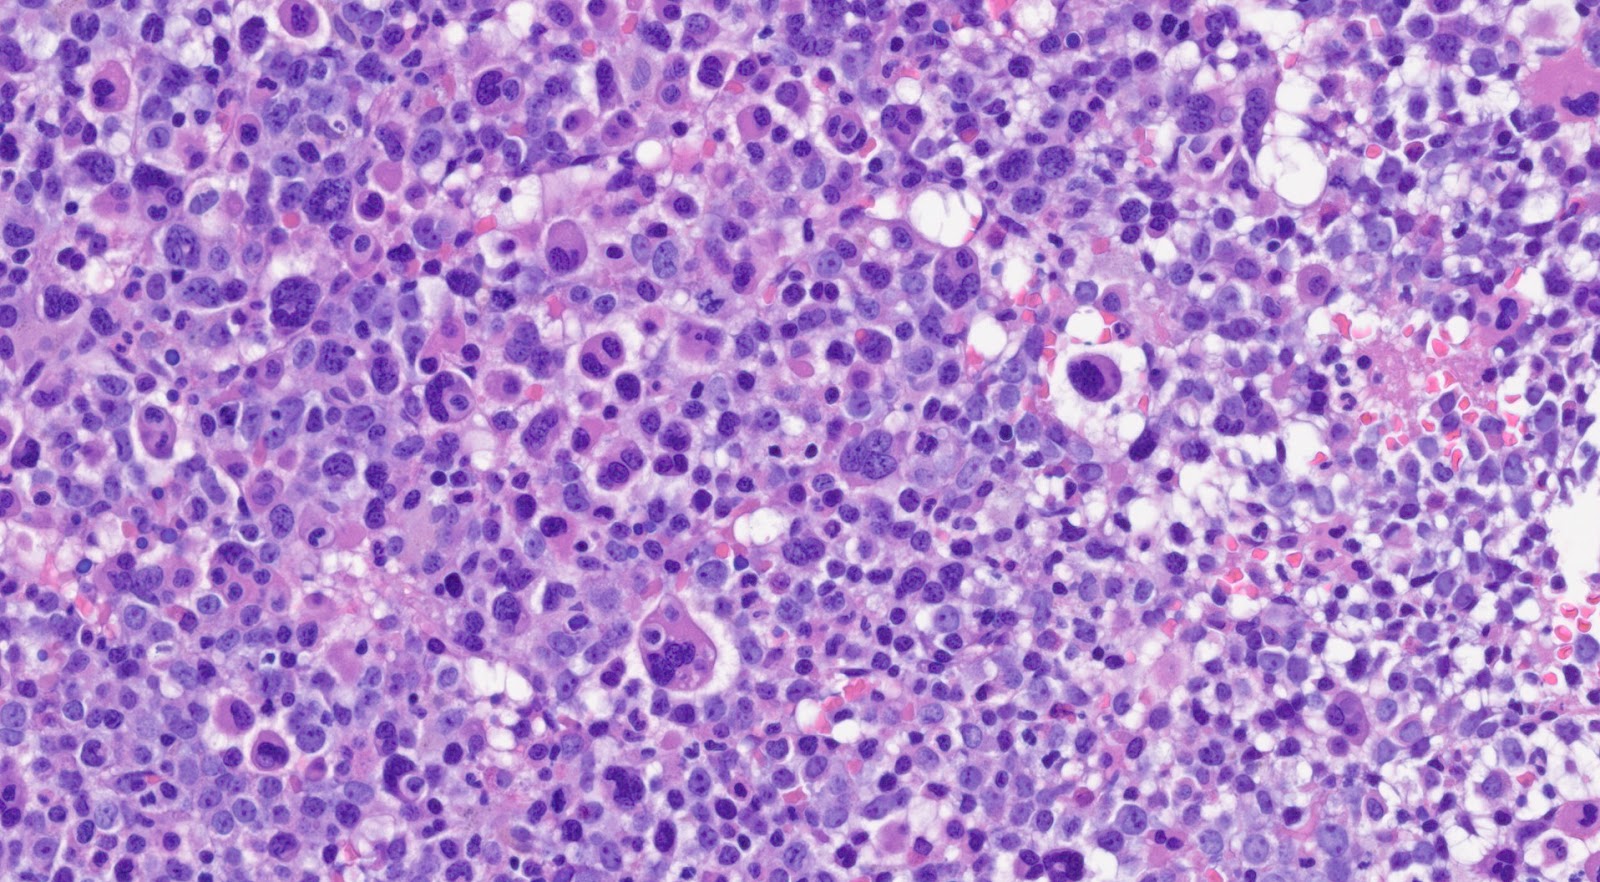

Chronic myeloid leukaemia
Haematolymphoid Tumours (WHO Classification, 5th ed.)
| This page is under construction |
editContent Update To WHO 5th Edition Classification Is In Process; Content Below is Based on WHO 4th Edition ClassificationThis page was converted to the new template on 2023-12-07. The original page can be found at HAEM4:Chronic Myeloid Leukemia (CML), BCR-ABL1 Positive.
(General Instructions – The focus of these pages is the clinically significant genetic alterations in each disease type. This is based on up-to-date knowledge from multiple resources such as PubMed and the WHO classification books. The CCGA is meant to be a supplemental resource to the WHO classification books; the CCGA captures in a continually updated wiki-stye manner the current genetics/genomics knowledge of each disease, which evolves more rapidly than books can be revised and published. If the same disease is described in multiple WHO classification books, the genetics-related information for that disease will be consolidated into a single main page that has this template (other pages would only contain a link to this main page). Use HUGO-approved gene names and symbols (italicized when appropriate), HGVS-based nomenclature for variants, as well as generic names of drugs and testing platforms or assays if applicable. Please complete tables whenever possible and do not delete them (add N/A if not applicable in the table and delete the examples); to add (or move) a row or column in a table, click nearby within the table and select the > symbol that appears. Please do not delete or alter the section headings. The use of bullet points alongside short blocks of text rather than only large paragraphs is encouraged. Additional instructions below in italicized blue text should not be included in the final page content. Please also see Author_Instructions and FAQs as well as contact your Associate Editor or Technical Support.)
Primary Author(s)*
Jack Reid, MD (University of California, Irvine)
Mark Evans, MD (University of California, Irvine)
Fabiola Quintero-Rivera, MD (University of California, Irvine)
WHO Classification of Disease
| Structure | Disease |
|---|---|
| Book | Haematolymphoid Tumours (5th ed.) |
| Category | Myeloid proliferations and neoplasms |
| Family | Myeloproliferative neoplasms |
| Type | Myeloproliferative neoplasms |
| Subtype(s) | Chronic myeloid leukaemia |
Definition / Description of Disease
Chronic myeloid leukemia (CML) is a myeloproliferative neoplasm that is characterized by clonal expansion of predominantly granulocytic proliferation (neutrophils, eosinophils and basophils). The majority of the patients with CML are known to have a gene rearrangement called the Philadelphia Chromosome, which is a balanced genetic translocation t(9;22)(q34.1;q11.2) involving a fusion of the Abelson gene (ABL1) from chromosome 9q34 with the breakpoint cluster region (BCR) gene on chromosome 22q11.2. Althought 80% of the clonal evolution in CML cases can be attributed to classic Ph chromosome, secondary cytogenetic aberrations can be seen such as isochromosome 17q, gain of chromosome 8 or 19. ML was first recognized in 1845[1]. Nowell and Hungerford in 1960, who coined the term Philadelphia Chromosome after realizing consistent chromosomal abnormality in leukemic cells.[2] Later in 1973, the characteristic cytogenetic feature of CML was identified: reciprocal translocation of t(9;22)(q34.1;q11.2).[3] CML has the capacity to expand in both myeloid and lymphoid lineages. However, expansion is predominantly in the granulocyte compartment of the myeloid lineages in the bone marrow.[4] In the previous WHO 4th edition, CML was be divided into 3 phases of disease: chronic phase, accelerated phase and blastic phase. Currently, in the revised classification of CML, AP at diagnosis or during treatment has been omitted and replaced by recognising only the chronic and blast phases
Synonyms / Terminology
Formerly chronic myelogenous leukemia or chronic granulocytic leukemia
Epidemiology / Prevalence
Global annual incidence of CML is 1-2 cases per 100,000 population. CML has male predominance with male to female ratio of 1.4:1. The prevalence of CML is increasing due to successful Tyrosine kinase inhibitor (TKI) therapy. Predilection of CML among certain ethnic groups has not been reported.[5] Regional variations in age at diagnosis and overall survival among patients with chronic myeloid leukemia from low and middle income countries.[6] The median age of patients diagnosed with CML is 66 years according to Surveillance, Epidemiology, and End Results (SEER) program and Medical Research Council (MRC) data. Although the etiology of CML is largely unknown, cases of CML have been reported in association with radiation exposure. No studies have shown any genetic inheritance of CML.
Clinical Features
Put your text here and fill in the table (Instruction: Can include references in the table. Do not delete table.)
| Signs and Symptoms | EXAMPLE: Asymptomatic (incidental finding on complete blood counts)
EXAMPLE: B-symptoms (weight loss, fever, night sweats) EXAMPLE: Fatigue EXAMPLE: Lymphadenopathy (uncommon) |
| Laboratory Findings | EXAMPLE: Cytopenias
EXAMPLE: Lymphocytosis (low level) |
editv4:Clinical FeaturesThe content below was from the old template. Please incorporate above.
Approximately 50% of the patients who are diagnosed with CML are asymptomatic and diagnosed during the routine blood tests.[7] CML is a hematological disease that occurs predominantly in adults but in rare cases, it can occur in the pediatric population.[8] The onset of CML is insidious. Patients with CML usually experience dragging sensation of the abdomen due to splenomegaly. The clinical hallmark of CML is the uncontrolled proliferation of mature and maturing granulocytes at all stages of maturation: metamyelocytes, myelocytes, promyelocytes, and myeloblasts. Patients with CML usually begin with the initial chronic phase before entering the terminal blastic phase and 60-80% of the patients go through accelerated phase before reaching the terminal blastic phase. In chronic phase, CML patients show abnormal routine blood tests with clinical symptoms such as unintentional weight loss, loss of appetite, satiety, fatigue, insomnia and palpable splenomegaly. In rare cases, hyperviscosity syndrome can be a manifestation with a wide spectrum of features such as priapism, tinnitus, hearing loss, cerebral accidents and blindness. In the blastic phase, CML leukemic cells resemble acute leukemic cells morphologically. CNS and lymph node involvement are notable in the blastic phase of CML. If untreated, CML patients will progress to the terminal blastic phase in 3 to 5 years.
End of V4 Section
Sites of Involvement
Spleen is known to be the most common site of involvement as patients with CML usually present with splenomegaly. Literature has shown that bone marrow is always involved in patients with CML.
Morphologic Features
Morphologically, peripheral blood smear shows the classic features of chronic-phase CML: granulocytic leukocytosis with left shift, neutrophilia, no increase in blasts, myelocyte “bulge” and basophilia.[9] Granulocytes seen in CML patients usually lack dysplastic features. In bone marrow, the aspirate smear shows classic features of CML: marked increase in neutrophils and precursors with a myeloid: erythroid ratio of > 10:1 and small hypolobated megakaryocytes. CML can sometimes present with thrombocytosis in peripheral blood smear, mimicking essential thrombocythemia (ET). Most of the time, primary myelofibrosis (PMF) share overlapping morphological features with CML in the peripheral blood; one distinguishing feature is that the megakaryocyte morphology in PMF is large, bizarre, and hyperchromatic, which is the feature not seen in the CML.
Immunophenotype
The role of immunohistochemistry is minimal in diagnosing CML. CML usually shows blastic markers (CD 34, CD 117, TdT), which can be useful to confirm extramedullary (splenic involvement with blastic transformation). Lineage-specific markers (MPO, lysosome, CD42b, CD79a, PAX5, CD3) are helpful in distinguishing among myeloid, lymphoid or megakaryocytic transformation.
| Finding | Marker |
|---|---|
| Positive | CD34 |
| Positive | CD117 |
|
Positive |
Tdt |
WHO Essential and Desirable Genetic Diagnostic Criteria
(Instructions: The table will have the diagnostic criteria from the WHO book autocompleted; remove any non-genetics related criteria. If applicable, add text about other classification systems that define this entity and specify how the genetics-related criteria differ.)
| WHO Essential Criteria (Genetics)* | |
| WHO Desirable Criteria (Genetics)* | |
| Other Classification |
*Note: These are only the genetic/genomic criteria. Additional diagnostic criteria can be found in the WHO Classification of Tumours.
Related Terminology
(Instructions: The table will have the related terminology from the WHO autocompleted.)
| Acceptable | |
| Not Recommended |
Gene Rearrangements
Put your text here and fill in the table (Instructions: Details on clinical significance such as prognosis and other important information can be provided in the notes section. Please include references throughout the table. Do not delete the table.)
| Driver Gene | Fusion(s) and Common Partner Genes | Molecular Pathogenesis | Typical Chromosomal Alteration(s) | Prevalence -Common >20%, Recurrent 5-20% or Rare <5% (Disease) | Diagnostic, Prognostic, and Therapeutic Significance - D, P, T | Established Clinical Significance Per Guidelines - Yes or No (Source) | Clinical Relevance Details/Other Notes |
|---|---|---|---|---|---|---|---|
| EXAMPLE: ABL1 | EXAMPLE: BCR::ABL1 | EXAMPLE: The pathogenic derivative is the der(22) resulting in fusion of 5’ BCR and 3’ABL1. | EXAMPLE: t(9;22)(q34;q11.2) | EXAMPLE: Common (CML) | EXAMPLE: D, P, T | EXAMPLE: Yes (WHO, NCCN) | EXAMPLE:
The t(9;22) is diagnostic of CML in the appropriate morphology and clinical context (add reference). This fusion is responsive to targeted therapy such as Imatinib (Gleevec) (add reference). BCR::ABL1 is generally favorable in CML (add reference). |
| EXAMPLE: CIC | EXAMPLE: CIC::DUX4 | EXAMPLE: Typically, the last exon of CIC is fused to DUX4. The fusion breakpoint in CIC is usually intra-exonic and removes an inhibitory sequence, upregulating PEA3 genes downstream of CIC including ETV1, ETV4, and ETV5. | EXAMPLE: t(4;19)(q25;q13) | EXAMPLE: Common (CIC-rearranged sarcoma) | EXAMPLE: D | EXAMPLE:
DUX4 has many homologous genes; an alternate translocation in a minority of cases is t(10;19), but this is usually indistinguishable from t(4;19) by short-read sequencing (add references). | |
| EXAMPLE: ALK | EXAMPLE: ELM4::ALK
|
EXAMPLE: Fusions result in constitutive activation of the ALK tyrosine kinase. The most common ALK fusion is EML4::ALK, with breakpoints in intron 19 of ALK. At the transcript level, a variable (5’) partner gene is fused to 3’ ALK at exon 20. Rarely, ALK fusions contain exon 19 due to breakpoints in intron 18. | EXAMPLE: N/A | EXAMPLE: Rare (Lung adenocarcinoma) | EXAMPLE: T | EXAMPLE:
Both balanced and unbalanced forms are observed by FISH (add references). | |
| EXAMPLE: ABL1 | EXAMPLE: N/A | EXAMPLE: Intragenic deletion of exons 2–7 in EGFR removes the ligand-binding domain, resulting in a constitutively active tyrosine kinase with downstream activation of multiple oncogenic pathways. | EXAMPLE: N/A | EXAMPLE: Recurrent (IDH-wildtype Glioblastoma) | EXAMPLE: D, P, T | ||
editv4:Chromosomal Rearrangements (Gene Fusions)The content below was from the old template. Please incorporate above.
CML is the first cancer that is known to be linked to a specific genetic abnormality, namely the balanced chromosomal translocation known as Philadelphia Chromosome. A focal gene area of BCR (Breakpoint Cluster Region) from chromosome 22 is fused with another gene ABL (Tyrosine protein kinase ABL) that is located on chromosome 9. The chimeric oncogene BCR-ABL is the central to the pathology of CML because ABL carries a domain that is capable of phosphorylating tyrosine residues, activating a cascade of proteins that control the cell cycle. It was reported that 90% - 95% of the CML in chronic phase shows characteristic t(9;22)(q34;q11.2) reciprocal translocation that results in the Ph chromosome. This balanced translocation leads to the formation of the BCR/ABL fusion gene on chromosome 22 and a reciprocal ABL/BCR fusion gene on chromosome 9. Studies has shown that the latter gene ABL/BCR fusion gene does not seem to have any crucial role in CML and no ABL/BCR protein has been found.
| Chromosomal Rearrangement | Genes in Fusion (5’ or 3’ Segments) | Prevalence |
|---|---|---|
| t(9;22)(q34.1;q11.2) | 3'ABL1 / 5'BCR | More than 90% |
End of V4 Section
editv4:Clinical Significance (Diagnosis, Prognosis and Therapeutic Implications).Please incorporate this section into the relevant tables found in:
- Chromosomal Rearrangements (Gene Fusions)
- Individual Region Genomic Gain/Loss/LOH
- Characteristic Chromosomal Patterns
- Gene Mutations (SNV/INDEL)
Diagnosis:
Currently four FDA approved tyrosine kinase inhibitors (TKIs) - imatinib, nilotinib, dasatinib and bosutinib - are the first line of treatment for patients with newly diagnosed CML in chronic phase (CML-CP).[10] For many years, inhibitors of the specific BCR-ABL1 tyrosine kinase are considered to be the most effective targeted therapy. A subset of CML patients can demonstrate resistance to TKI therapy through mutations in ABL1 and other mechanisms. The culprit of the resistance to TKI therapy can be attributed to so-called leukemic stem cells (LSCs), pluripotent BCR-ABL1+ progenitors that are largely quiescent.[11] Therefore, understanding of signaling pathways related to survival of LSCs may be helpful.
Prognosis: Acquired resistance to imatinib therapy , mostly with mutation in BCR-ABL kinase domain, is known to be associated with poor prognosis.[12] Five prognostic factors were shown to be associated with major cytogenetic response: the absence of blasts in peripheral blood, a hemoglobin level of more than 12 g per deciliter, the presence of less than 5 percent blasts in marrow, a time from diagnosis of CML to start of treatment of less than one year, and a history of cytogenetic relapse during interferon therapy.[13]
Therapeutic implication: Studies have shown that median survival
Complete cytogenetic response is defined as 0% of Philadelphia-chromosome (Ph)-positive cells in metaphase in bone marrow.[14]
End of V4 Section
Individual Region Genomic Gain/Loss/LOH
Put your text here and fill in the table (Instructions: Includes aberrations not involving gene rearrangements. Details on clinical significance such as prognosis and other important information can be provided in the notes section. Can refer to CGC workgroup tables as linked on the homepage if applicable. Please include references throughout the table. Do not delete the table.)
| Chr # | Gain, Loss, Amp, LOH | Minimal Region Cytoband and/or Genomic Coordinates [Genome Build; Size] | Relevant Gene(s) | Diagnostic, Prognostic, and Therapeutic Significance - D, P, T | Established Clinical Significance Per Guidelines - Yes or No (Source) | Clinical Relevance Details/Other Notes |
|---|---|---|---|---|---|---|
| EXAMPLE:
7 |
EXAMPLE: Loss | EXAMPLE:
chr7 |
EXAMPLE:
Unknown |
EXAMPLE: D, P | EXAMPLE: No | EXAMPLE:
Presence of monosomy 7 (or 7q deletion) is sufficient for a diagnosis of AML with MDS-related changes when there is ≥20% blasts and no prior therapy (add reference). Monosomy 7/7q deletion is associated with a poor prognosis in AML (add references). |
| EXAMPLE:
8 |
EXAMPLE: Gain | EXAMPLE:
chr8 |
EXAMPLE:
Unknown |
EXAMPLE: D, P | EXAMPLE:
Common recurrent secondary finding for t(8;21) (add references). | |
| EXAMPLE:
17 |
EXAMPLE: Amp | EXAMPLE:
17q12; chr17:39,700,064-39,728,658 [hg38; 28.6 kb] |
EXAMPLE:
ERBB2 |
EXAMPLE: D, P, T | EXAMPLE:
Amplification of ERBB2 is associated with HER2 overexpression in HER2 positive breast cancer (add references). Add criteria for how amplification is defined. | |
editv4:Genomic Gain/Loss/LOHThe content below was from the old template. Please incorporate above.
Not Applicable.
End of V4 Section
Characteristic Chromosomal or Other Global Mutational Patterns
Put your text here and fill in the table (Instructions: Included in this category are alterations such as hyperdiploid; gain of odd number chromosomes including typically chromosome 1, 3, 5, 7, 11, and 17; co-deletion of 1p and 19q; complex karyotypes without characteristic genetic findings; chromothripsis; microsatellite instability; homologous recombination deficiency; mutational signature pattern; etc. Details on clinical significance such as prognosis and other important information can be provided in the notes section. Please include references throughout the table. Do not delete the table.)
| Chromosomal Pattern | Molecular Pathogenesis | Prevalence -
Common >20%, Recurrent 5-20% or Rare <5% (Disease) |
Diagnostic, Prognostic, and Therapeutic Significance - D, P, T | Established Clinical Significance Per Guidelines - Yes or No (Source) | Clinical Relevance Details/Other Notes |
|---|---|---|---|---|---|
| EXAMPLE:
Co-deletion of 1p and 18q |
EXAMPLE: See chromosomal rearrangements table as this pattern is due to an unbalanced derivative translocation associated with oligodendroglioma (add reference). | EXAMPLE: Common (Oligodendroglioma) | EXAMPLE: D, P | ||
| EXAMPLE:
Microsatellite instability - hypermutated |
EXAMPLE: Common (Endometrial carcinoma) | EXAMPLE: P, T | |||
editv4:Characteristic Chromosomal Aberrations / PatternsThe content below was from the old template. Please incorporate above.
Atypical chronic myeloid leukemia (aCML) is a subtype of myelodysplastic/myeloproliferative neoplasm that lacks Philadelphia chromosome or rearrangements of PDGFRA, PDGFRB, or FGFR1. This hematological disorder has a considerable overlapping clinicopathological features with CML and CMML. It differs from CML by older median age, lower level of granulocytosis, multilineage dysplasia and lack of basophilia. Up until now, no cytogenetic changes have been associated with aCML. In peripheral blood smear, aCML typically shows granulocytic leukocytosis with striking neutrophil dysplasia (nuclear hyposegmentation and hypogranularity).
End of V4 Section
Gene Mutations (SNV/INDEL)
Put your text here and fill in the table (Instructions: This table is not meant to be an exhaustive list; please include only genes/alterations that are recurrent or common as well either disease defining and/or clinically significant. If a gene has multiple mechanisms depending on the type or site of the alteration, add multiple entries in the table. For clinical significance, denote associations with FDA-approved therapy (not an extensive list of applicable drugs) and NCCN or other national guidelines if applicable; Can also refer to CGC workgroup tables as linked on the homepage if applicable as well as any high impact papers or reviews of gene mutations in this entity. Details on clinical significance such as prognosis and other important information such as concomitant and mutually exclusive mutations can be provided in the notes section. Please include references throughout the table. Do not delete the table.)
| Gene | Genetic Alteration | Tumor Suppressor Gene, Oncogene, Other | Prevalence -
Common >20%, Recurrent 5-20% or Rare <5% (Disease) |
Diagnostic, Prognostic, and Therapeutic Significance - D, P, T | Established Clinical Significance Per Guidelines - Yes or No (Source) | Clinical Relevance Details/Other Notes |
|---|---|---|---|---|---|---|
| EXAMPLE:EGFR
|
EXAMPLE: Exon 18-21 activating mutations | EXAMPLE: Oncogene | EXAMPLE: Common (lung cancer) | EXAMPLE: T | EXAMPLE: Yes (NCCN) | EXAMPLE: Exons 18, 19, and 21 mutations are targetable for therapy. Exon 20 T790M variants cause resistance to first generation TKI therapy and are targetable by second and third generation TKIs (add references). |
| EXAMPLE: TP53; Variable LOF mutations
|
EXAMPLE: Variable LOF mutations | EXAMPLE: Tumor Supressor Gene | EXAMPLE: Common (breast cancer) | EXAMPLE: P | EXAMPLE: >90% are somatic; rare germline alterations associated with Li-Fraumeni syndrome (add reference). Denotes a poor prognosis in breast cancer. | |
| EXAMPLE: BRAF; Activating mutations | EXAMPLE: Activating mutations | EXAMPLE: Oncogene | EXAMPLE: Common (melanoma) | EXAMPLE: T | ||
Note: A more extensive list of mutations can be found in cBioportal, COSMIC, and/or other databases. When applicable, gene-specific pages within the CCGA site directly link to pertinent external content.
editv4:Gene Mutations (SNV/INDEL)The content below was from the old template. Please incorporate above.
A few genes were noted to be altered during the transformed stages of CML, namely TP53, RB1, MYC, CDKN2A, NRAS, KRAS, RUNX1, MECOM, TET2, CBL, ASXL1, IDH1 and IDH2.
End of V4 Section
Epigenomic Alterations
Not Applicable.
Genes and Main Pathways Involved
Put your text here and fill in the table (Instructions: Please include references throughout the table. Do not delete the table.)
| Gene; Genetic Alteration | Pathway | Pathophysiologic Outcome |
|---|---|---|
| EXAMPLE: BRAF and MAP2K1; Activating mutations | EXAMPLE: MAPK signaling | EXAMPLE: Increased cell growth and proliferation |
| EXAMPLE: CDKN2A; Inactivating mutations | EXAMPLE: Cell cycle regulation | EXAMPLE: Unregulated cell division |
| EXAMPLE: KMT2C and ARID1A; Inactivating mutations | EXAMPLE: Histone modification, chromatin remodeling | EXAMPLE: Abnormal gene expression program |
editv4:Genes and Main Pathways InvolvedThe content below was from the old template. Please incorporate above.

Breakpoint Cluster Region protein (BCR) is encoded by BCR gene, located on chromosome 22. BCR protein has serine/threonine kinase activity.[7] The protein is also a GTPase-activating protein for p21rac and other kinases.[15] BCR protein is involved in the two main pathways: FGFR1 mutant receptor activation and G-protein signaling HRAS regulation pathway.[16] BCR-associated genetic rearrangement gives rise to hematological disorders. The ABL1 gene is located on chromosome 9q34.12 and encodes for ABL1 protein, which was discovered to be a tyrosine kinase protein.[17] Depending on the breakpoint of the BCR gene, the size of the fusion protein can vary: p190bcr-abl, p210bcr-abl, and p230bcr-abl, leading to three different isoforms.[7] BCR-ABL1 gene fusion encodes a chimeric protein, which is mostly 210 kDa(P210BCRABL1) with constitutive tyrosine-kinase activity, escaping the cytokine regulation and regulatory controls of many intracellular signaling pathways that are associated with proliferation, differentiation and apoptosis.[18][19] Many of the target proteins that are affected by dimerization of constitutive kinase activity of BCR-ABL fusion protein include STAT, RAS, RAF, JUN kinase, MYC, AKT, and other transducers.[20][21] It was shown that when CML progresses to the blastic crisis phase, a new additional mutation is acquired GSK3beta, which leads to the activation of beta-catenin, preventing myeloid cell lineages to mature.[22][23]

End of V4 Section
Genetic Diagnostic Testing Methods
Majority of the patients with CML are initially diagnosed through a blood test - complete blood count - before clinical manifestations. Bone marrow aspirate and core biopsy are performed sequentially to further support the process of making diagnosis as well as assessing percentage of blasts and basophils.[24] Histologic features of CML in the peripheral blood are helpful in deriving the CML diagnosis. Ancillary tests are performed to clinch the diagnosis: immunohistochemistry, flow cytometry, conventional cytogenetic analysis, FISH and molecular RT-PCR-based studies.
Cytogenetic testing is used in CML patients to monitor how patients are responding to the treatment by detecting the number of cells with the Philadelphia chromosome. In conjunction with cytogenetic testing, FISH and PCR are ordered to quantify treatment monitoring processes in CML. FISH allows the detection of BCR-ABL gene, which is essentially considered to be more of a sensitive test compared to cytogenetic testing. PCR is performed to find BCR-ABL fusion gene and other molecular abnormalities. PCR is very efficient because it can detect even one abnormal cell from approximately 1 million healthy cells. FISH can be used in rare cases where molecular transcripts are not detected.
Continuous monitoring is part of the standard of care in CML patients because it allows the clinicians to identify treatment failure, disease evolution and drug regimen adherence. Minimal residual disease monitoring is done by using RT-PCR. Major molecular response (MMR) is the critical goal of CML treatment. Complete or deep molecular response is achieved when there is absence of BCR-ABL1 transcript or >4.5 logs below baseline level.[25]
Familial Forms
Not Applicable.
Additional Information
Put your text here
Links
References
(use the "Cite" icon at the top of the page) (Instructions: Add each reference into the text above by clicking where you want to insert the reference, selecting the “Cite” icon at the top of the wiki page, and using the “Automatic” tab option to search by PMID to select the reference to insert. If a PMID is not available, such as for a book, please use the “Cite” icon, select “Manual” and then “Basic Form”, and include the entire reference. To insert the same reference again later in the page, select the “Cite” icon and “Re-use” to find the reference; DO NOT insert the same reference twice using the “Automatic” tab as it will be treated as two separate references. The reference list in this section will be automatically generated and sorted.)
- ↑ Jm, Goldman; et al. (2003). "Chronic Myeloid Leukemia--Advances in Biology and New Approaches to Treatment". PMID 14534339.
- ↑ Nowell, Peter C. (2007). "Discovery of the Philadelphia chromosome: a personal perspective". Journal of Clinical Investigation. 117 (8): 2033–2035. doi:10.1172/JCI31771. ISSN 0021-9738. PMC 1934591. PMID 17671636.
- ↑ Jd, Rowley (1973). "Letter: A New Consistent Chromosomal Abnormality in Chronic Myelogenous Leukaemia Identified by Quinacrine Fluorescence and Giemsa Staining". PMID 4126434.
- ↑ S, Faderl; et al. (1999). "The Biology of Chronic Myeloid Leukemia". PMID 10403855.
- ↑ Jv, Melo; et al. (1993). "The ABL-BCR Fusion Gene Is Expressed in Chronic Myeloid Leukemia". PMID 8417787.
- ↑ Am, Mendizabal; et al. (2013). "Regional Variations in Age at Diagnosis and Overall Survival Among Patients With Chronic Myeloid Leukemia From Low and Middle Income Countries". PMID 23411044.
- ↑ 7.0 7.1 7.2 Silver RT. Molecular Biology of CML. In: Kufe DW, Pollock RE, Weichselbaum RR, et al., editors. Holland-Frei Cancer Medicine. 6th edition. Hamilton (ON): BC Decker; 2003. Available from: https://www.ncbi.nlm.nih.gov/books/NBK13554/
- ↑ Am, Mendizabal; et al. (2013). "Regional Variations in Age at Diagnosis and Overall Survival Among Patients With Chronic Myeloid Leukemia From Low and Middle Income Countries". PMID 23411044.
- ↑ Vardiman JW, et al., (2016). Chronic myeloid leukaemia, BCR-ABL1-positive, in World Health Organization Classification of Tumours of Haematopoietic and Lymphoid Tissues, Revised 4th edition. Swerdlow SH, Campo E, Harris NL, et al., Editors. IARC Press: Lyon, France, p30-36.
- ↑ Ja, Kennedy; et al. (2018). "Tyrosine Kinase Inhibitors in the Treatment of Chronic-Phase CML: Strategies for Frontline Decision-making". doi:10.1007/s11899-018-0449-7. PMC 6023770. PMID 29687320.CS1 maint: PMC format (link)
- ↑ S, Tabarestani; et al. (2016). "New Developments in Chronic Myeloid Leukemia: Implications for Therapy". doi:10.17795/ijcp-3961. PMC 4922205. PMID 27366312.CS1 maint: PMC format (link)
- ↑ S, Branford; et al. (2003). "Detection of BCR-ABL Mutations in Patients With CML Treated With Imatinib Is Virtually Always Accompanied by Clinical Resistance, and Mutations in the ATP Phosphate-Binding Loop (P-loop) Are Associated With a Poor Prognosis". PMID 12623848.
- ↑ H, Kantarjian; et al. (2002). "Hematologic and Cytogenetic Responses to Imatinib Mesylate in Chronic Myelogenous Leukemia". PMID 11870241.
- ↑ J, Cortes; et al. (2011). "Monitoring Molecular Response in Chronic Myeloid Leukemia". doi:10.1002/cncr.25527. PMC 4969001. PMID 20960522.CS1 maint: PMC format (link)
- ↑ "BCR BCR activator of RhoGEF and GTPase [Homo sapiens (human)] - Gene - NCBI".
- ↑ Mn, Peiris; et al. (2019). "BCR: A Promiscuous Fusion Partner in Hematopoietic Disorders". doi:10.18632/oncotarget.26837. PMC 6505627. PMID 31105873.CS1 maint: PMC format (link)
- ↑ B, Chereda; et al. (2015). "Natural Course and Biology of CML". PMID 25814077.
- ↑ Jb, Konopka; et al. (1984). "An Alteration of the Human C-Abl Protein in K562 Leukemia Cells Unmasks Associated Tyrosine Kinase Activity". PMID 6204766.
- ↑ R, Ren (2005). "Mechanisms of BCR-ABL in the Pathogenesis of Chronic Myelogenous Leukaemia". PMID 15719031.
- ↑ S, Faderl; et al. (1999). "The Biology of Chronic Myeloid Leukemia". PMID 10403855.
- ↑ Cl, Sawyers (1999). "Chronic Myeloid Leukemia". PMID 10219069.
- ↑ Ch, Jamieson; et al. (2004). "Granulocyte-macrophage Progenitors as Candidate Leukemic Stem Cells in Blast-Crisis CML". PMID 15306667.
- ↑ Ae, Abrahamsson; et al. (2009). "Glycogen Synthase Kinase 3beta Missplicing Contributes to Leukemia Stem Cell Generation". doi:10.1073/pnas.0900189106. PMC 2646624. PMID 19237556.CS1 maint: PMC format (link)
- ↑ E, Jabbour; et al. (2018). "Chronic Myeloid Leukemia: 2018 Update on Diagnosis, Therapy and Monitoring". PMID 29411417.
- ↑ gknation (2015). "Treatment Outcomes".
Notes
*Primary authors will typically be those that initially create and complete the content of a page. If a subsequent user modifies the content and feels the effort put forth is of high enough significance to warrant listing in the authorship section, please contact the Associate Editor or other CCGA representative. When pages have a major update, the new author will be acknowledged at the beginning of the page, and those who contributed previously will be acknowledged below as a prior author.
Prior Author(s):
*Citation of this Page: “Chronic myeloid leukaemia”. Compendium of Cancer Genome Aberrations (CCGA), Cancer Genomics Consortium (CGC), updated 02/10/2025, https://ccga.io/index.php/HAEM5:Chronic_myeloid_leukaemia.